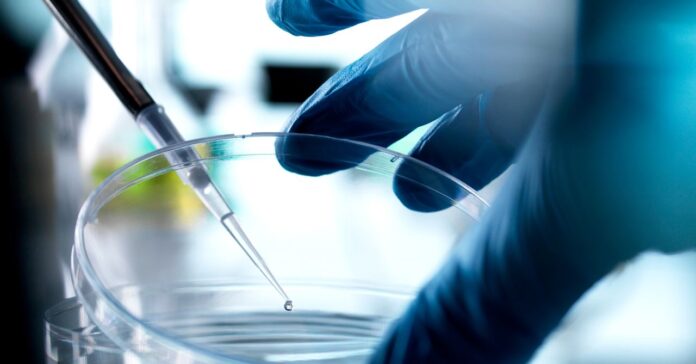
Florida-Is-Now-a-Haven-for-Unproven-Stem-Cell-Treatments.jpg

Florida is the latest state to sidestep the authority of the Food and Drug Administration by allowing patients to access certain stem-cell treatments that have not been rigorously evaluated and approved.
Under a new law that went into effect July 1, doctors in Florida can administer unapproved stem-cell therapies for wound care, pain management, or orthopedic purposes. The law comes amid growing support for medical freedom in the United States, an idea espoused by Health and Human Services secretary Robert F. Kennedy Jr., and it could prompt other states to follow. Supporters say the law helps protect patients, while critics argue it opens the door for physical and financial harm.
“There is interest in various states in enabling the sale of stem-cell products that have not been approved by the FDA,” says Leigh Turner, a bioethicist and professor of health, society, and behavior at the University of California, Irvine, who has been tracking the stem-cell industry. “I think we’re going to see more of that.”
Last year, Utah passed a law allowing health care providers in the state to offer placental stem-cell therapies, which are often marketed for treating wounds and injuries, so long as they clearly note their unapproved status and get written informed consent from patients before administering them. And a 2017 law in Texas permits clinics and companies to offer unapproved stem-cell therapies to people with chronic or terminal diseases when conventional treatment options have been exhausted.
Stem cells have been of immense interest for the past 30 years because of their ability to produce copies of themselves indefinitely and form more specialized cells in the body. Stem cells are central to human development during pregnancy and can be found in embryos, placental tissue, and umbilical cord blood, and are also produced naturally by adults, particularly in bone marrow, to allow the body to repair itself. They have been studied as treatments for a wide variety of ailments over the years, including arthritis, diabetes, heart failure, multiple sclerosis, and Parkinson’s disease.
But despite decades of research, stem cells have not produced the kinds of cures that scientists had hoped for. The only products the FDA has approved are blood-forming stem cells sourced from umbilical cord blood. They are used in transplants to treat patients with certain cancers and blood and autoimmune disorders who have had their own blood-forming stem cells destroyed by high doses of chemotherapy or radiation.
The Florida law prohibits stem-cell therapies derived from embryos and classifies the use of embryonic stem cells as a third-degree felony. It also bans the use of cells taken from umbilical cords following abortions, although it allows cells to be sourced from discarded umbilical cords and placentas after live births.
The FDA regulates stem cell therapies as drugs unless they are “minimally manipulated,” meaning that any processing of the cells does not significantly alter their original relevant biological characteristics. This loophole has allowed clinics and companies to circumvent the years-long drug approval process and offer treatments of stem cells that have not been thoroughly tested for safety and efficacy. The Florida law does not specify whether stem cells offered in the state must be minimally manipulated, presumably allowing cells that are manipulated beyond that standard.